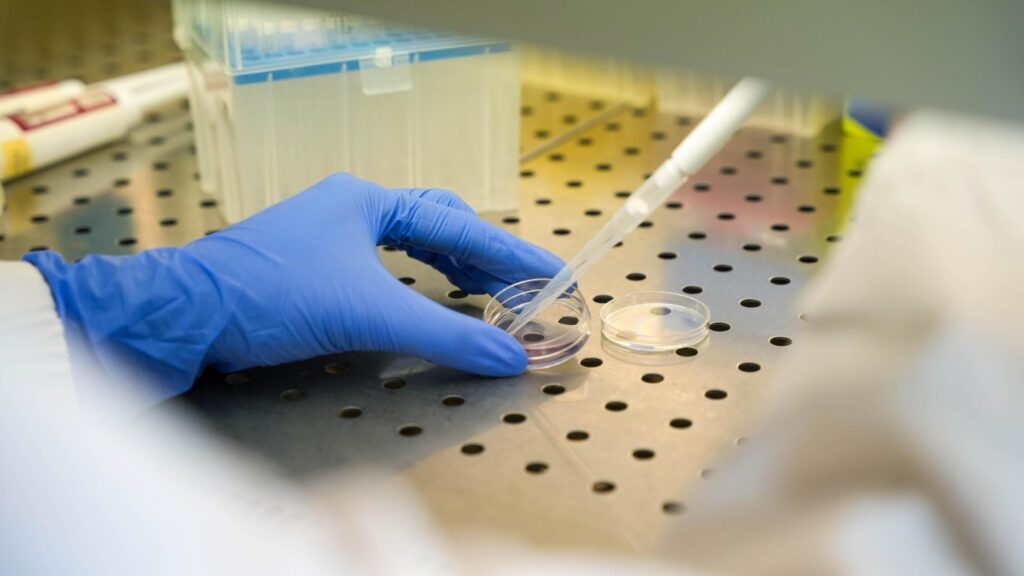

Taylor Swift si brevetta per proteggere la sua identità artistica dall'intelligenza artificiale. (ANSA)
E’ uscito il mio nuovo libro “GO – Codice di Impatto” al prezzo di 20 euro. È un libro dinamico, che cambia in continuazione e si anima in realtà aumentata; è un libro che guarda avanti, ed è in assoluto il primo che non si limita a parlare di innovazione, ma la promuove e la finanzia.
GIANCARLO ORSINI